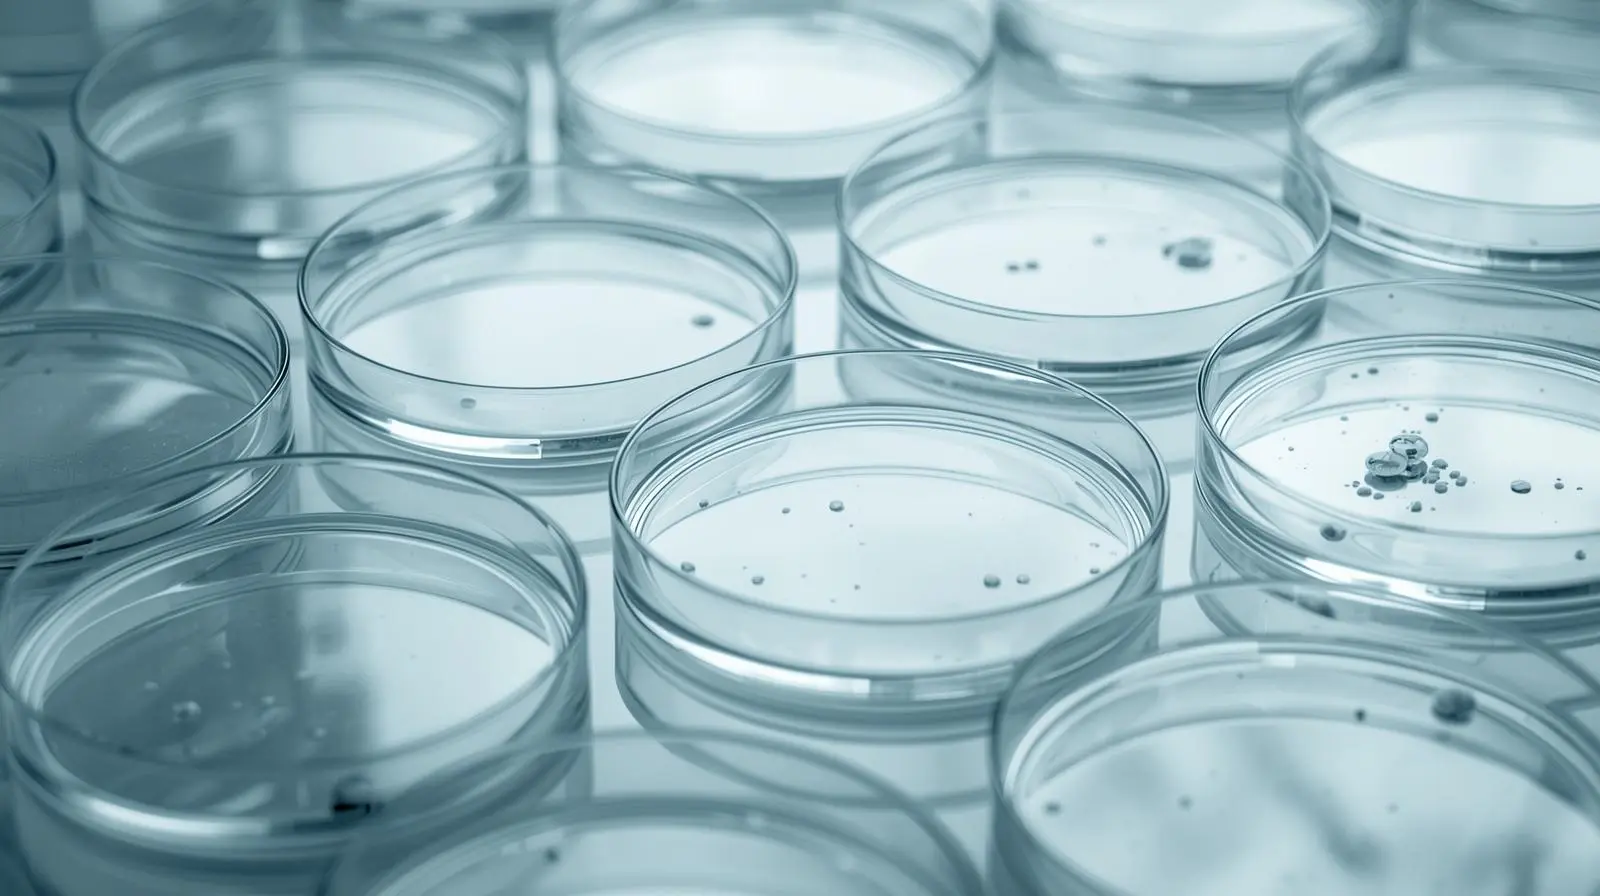
Petri dishes

Sulfur Chemical
We supply a wide selection of laboratory glassware and plasticware designed for accurate measurement, sample handling, and storage. Our products are durable, heat-resistant, and suitable for all lab environments.













Sulfur Chemical
We supply a wide selection of laboratory glassware and plasticware designed for accurate measurement, sample handling, and storage. Our products are durable, heat-resistant, and suitable for all lab environments.